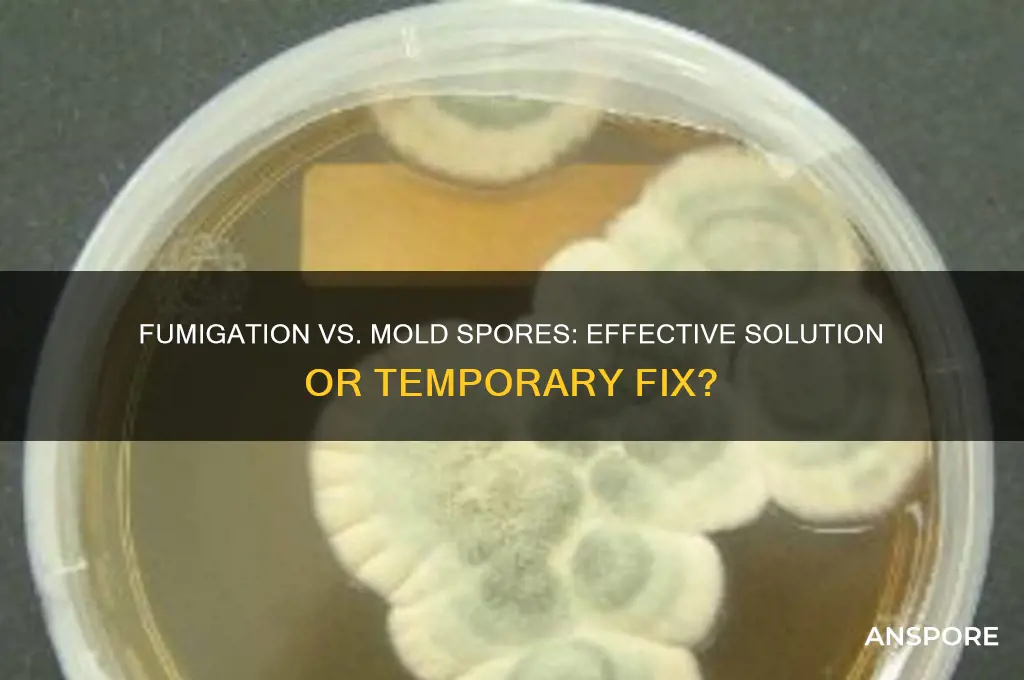
does fumigation kill mold spores

Fumigation is a common method used to eliminate pests and pathogens, but its effectiveness against mold spores is a topic of significant interest and debate. Mold spores are microscopic, resilient organisms that can survive in various environments, making them particularly challenging to eradicate. While fumigation involves the use of gases or chemicals to penetrate spaces and kill organisms, its success in eliminating mold spores depends on factors such as the type of fumigant used, the concentration, and the duration of exposure. Some fumigants, like chlorine dioxide or formaldehyde, may reduce mold spore populations, but they are not always guaranteed to eliminate all spores, especially those embedded in porous materials. Additionally, fumigation does not address the underlying moisture issues that foster mold growth, making it a temporary solution unless combined with proper remediation and prevention strategies. Understanding the limitations and potential of fumigation in mold control is crucial for effective and long-term management of mold-related problems.
| Characteristics | Values |
|---|---|
| Effectiveness on Mold Spores | Fumigation can reduce mold spores but is not always effective in killing all spores, especially if they are deeply embedded. |
| Method of Action | Fumigation uses chemicals (fumigants) to penetrate surfaces and kill organisms, including mold spores. |
| Common Fumigants Used | Chlorine dioxide, ozone, formaldehyde, and hydrogen peroxide. |
| Surface vs. Airborne Spores | More effective on airborne spores than on spores embedded in porous materials like wood or drywall. |
| Residual Mold Growth | Does not prevent future mold growth if moisture issues persist. |
| Health and Safety Concerns | Fumigation requires evacuation and proper ventilation due to toxic chemicals. |
| Cost | Generally expensive compared to other mold remediation methods. |
| Environmental Impact | Some fumigants are harmful to the environment and require careful disposal. |
| Alternatives | HEPA filtration, physical removal, and antimicrobial treatments are often preferred for mold remediation. |
| Regulations | Fumigation must comply with local health and safety regulations. |
| Long-Term Solution | Not a long-term solution without addressing underlying moisture problems. |
Explore related products
$13.48 $14.13
What You'll Learn

Effectiveness of fumigation on mold spores
Fumigation, a method often associated with pest control, is sometimes considered for mold remediation. However, its effectiveness on mold spores is a nuanced topic. Mold spores are microscopic and resilient, capable of surviving in harsh conditions. Fumigation involves the use of gaseous pesticides, or fumigants, which penetrate materials to eliminate pests. While these gases can reach areas that are difficult to access, their efficacy against mold spores depends on several factors, including the type of fumigant used, the concentration, and the duration of exposure. For instance, formaldehyde gas has been historically used for mold control, but its use is highly regulated due to health risks.
Analyzing the process, fumigation can reduce mold spore counts in certain environments, but it is not a guaranteed solution. Mold spores can remain dormant and reactivate once conditions become favorable. Additionally, fumigation does not address the underlying moisture issues that foster mold growth. For example, a study on the use of phosphine gas for mold control found that while it reduced spore counts, it did not eliminate the mold entirely, especially in porous materials where spores can embed deeply. This highlights the importance of combining fumigation with other remediation methods, such as moisture control and physical removal of mold-infested materials.
From a practical standpoint, if you are considering fumigation for mold, it is crucial to consult professionals who can assess the specific situation. DIY fumigation is not recommended due to the health risks associated with fumigants. For instance, exposure to high concentrations of formaldehyde can cause respiratory issues, skin irritation, and other health problems. Professionals typically use controlled environments and personal protective equipment (PPE) to ensure safety. Additionally, the area must be properly ventilated after fumigation to remove residual gases.
Comparatively, other mold remediation methods like HEPA vacuuming, scrubbing with antimicrobial agents, and UV light treatment are often more effective and safer for indoor environments. Fumigation may be more suitable for large-scale industrial settings or agricultural storage facilities where mold contamination is extensive and other methods are impractical. However, even in these cases, it should be part of a comprehensive approach that includes preventing future moisture accumulation.
In conclusion, while fumigation can reduce mold spore counts, it is not a standalone solution for mold remediation. Its effectiveness is limited by the resilience of mold spores and the inability to address the root cause of mold growth. For homeowners and businesses, focusing on moisture control, proper ventilation, and physical removal of mold-infested materials is generally more practical and sustainable. If fumigation is considered, it should be done by professionals and as part of a broader strategy to ensure long-term success.
Can You Spot Mold Spores on Clothes? A Quick Guide
You may want to see also

Types of fumigants used for mold control
Fumigation can indeed target mold spores, but not all fumigants are created equal in this task. The choice of fumigant depends on factors like the type of mold, the affected material, and the environment. Here’s a breakdown of the types of fumigants commonly used for mold control, their mechanisms, and practical considerations.
Chlorine-based fumigants, such as chlorine dioxide gas, are highly effective against mold spores due to their oxidative properties. They disrupt the cell walls of spores, rendering them inactive. Chlorine dioxide is often used in enclosed spaces like warehouses or shipping containers, where mold contamination is widespread. Application typically involves generating the gas on-site using a chemical reaction between sodium chlorite and an acid. Dosage varies based on the volume of the space and the severity of the infestation, but concentrations of 1–10 ppm over 24–48 hours are common. Caution is essential, as chlorine dioxide is toxic and requires professional handling to avoid exposure risks.
Formaldehyde, another potent fumigant, is widely used in museums and archives to protect paper, textiles, and other organic materials from mold. It works by denaturing proteins in mold spores, effectively killing them. Formaldehyde is applied as a gas or in liquid form, often in concentrations of 0.5–2.0% in water. However, its use is controversial due to its carcinogenic properties and strong odor. Proper ventilation and personal protective equipment (PPE) are critical during application. For sensitive materials, formaldehyde is often paired with controlled humidity levels to enhance its efficacy.
Ozone, a naturally occurring gas, is increasingly popular for mold remediation due to its eco-friendly profile. Ozone oxidizes mold spores, breaking them down at a molecular level. It’s particularly useful for treating air and surfaces in residential or commercial spaces. Ozone generators are used to produce high concentrations of the gas, typically 1–4 ppm, for several hours. However, ozone is harmful to humans and pets, so the treated area must be vacated during application. After treatment, the space should be ventilated to dissipate residual ozone before reoccupation.
Propylene oxide, though less common, is a powerful fumigant used in industrial settings for mold control. It penetrates porous materials effectively, making it ideal for treating items like insulation or wooden structures. Application involves heating the gas to 40–50°C and maintaining a concentration of 500–1000 ppm for 16–24 hours. Propylene oxide is highly flammable and requires strict safety protocols, including explosion-proof equipment and trained personnel. Its use is typically reserved for severe infestations where other methods have failed.
In summary, the choice of fumigant for mold control hinges on the specific needs of the situation. Chlorine dioxide and formaldehyde offer proven efficacy but come with health risks, while ozone provides a greener alternative with its own set of precautions. Propylene oxide, though potent, is best reserved for extreme cases. Each fumigant requires careful application and adherence to safety guidelines to ensure both effectiveness and safety.
Mastering Spore Print Storage: Essential Tips for Long-Term Preservation
You may want to see also

Duration of fumigation to kill spores
Fumigation duration for mold spore eradication varies significantly based on factors like the fumigant used, concentration, temperature, and mold species. For instance, methyl bromide, a common fumigant, typically requires 16 to 24 hours of exposure at concentrations of 40 to 80 grams per cubic meter to effectively kill mold spores. However, newer alternatives like phosphine or sulfuryl fluoride may demand longer durations, often 48 to 72 hours, due to their lower toxicity and slower penetration rates. Understanding these variables is crucial for tailoring fumigation protocols to specific mold infestations.
Instructive guidelines emphasize the importance of pre-fumigation preparation to maximize efficacy. Before initiating the process, ensure the area is sealed airtight to maintain fumigant concentration. Use gas monitoring equipment to verify that the fumigant reaches all infested surfaces, including hidden areas like wall cavities and crawl spaces. For residential settings, occupants, including pets, must vacate the premises for the entire duration, typically 24 to 72 hours, depending on the fumigant. Post-fumigation, aeration is critical; open all windows and doors, and use fans to dissipate residual gas, ensuring safe re-entry after air quality testing confirms clearance.
A comparative analysis reveals that while fumigation can be highly effective, its duration often exceeds that of alternative mold remediation methods. For example, ozone treatment, which neutralizes mold spores through oxidation, typically requires 4 to 6 hours but may not penetrate porous materials as effectively as fumigation. Similarly, HEPA filtration and manual removal are faster but labor-intensive and may not address airborne spores comprehensively. Fumigation’s longer duration is a trade-off for its ability to reach inaccessible areas, making it ideal for severe infestations where thorough eradication is non-negotiable.
Descriptively, the process of fumigation unfolds in stages, each critical to spore elimination. Initially, the fumigant is released into the sealed environment, gradually saturating the air and settling on surfaces. Over the prescribed duration, the gas penetrates materials, disrupting spore cell structures. Temperature plays a pivotal role; warmer conditions (above 68°F or 20°C) accelerate fumigant action, potentially reducing required exposure time. Conversely, colder environments may necessitate extended durations or higher concentrations. Monitoring humidity is equally vital, as excessive moisture can hinder fumigant efficacy by diluting its potency.
Persuasively, while fumigation’s duration may seem protracted, its thoroughness justifies the investment. Unlike surface treatments, fumigation addresses both visible mold and hidden spores, preventing recurrence. For commercial or industrial settings, the downtime associated with fumigation is often offset by the long-term savings from avoiding repeated remediation efforts. Homeowners, however, should weigh the inconvenience of extended displacement against the risk of incomplete mold removal. Consulting with a certified fumigation specialist can provide tailored advice, ensuring the chosen duration aligns with the infestation’s severity and the property’s specific needs.
Bacillaceae Sporulation: Understanding How This Bacterial Family Forms Spores
You may want to see also
Explore related products

Safety concerns during mold fumigation
Fumigation can indeed kill mold spores, but it’s not without risks. The chemicals used, such as chlorine dioxide or formaldehyde, are potent and can pose serious health hazards if not handled correctly. Exposure to these substances can cause respiratory issues, skin irritation, and even long-term health problems. For instance, formaldehyde is classified as a known human carcinogen by the International Agency for Research on Cancer (IARC). Understanding these risks is the first step in ensuring safety during mold fumigation.
Preparation is key to minimizing safety concerns. Before fumigation begins, all occupants, including pets, must vacate the premises. This is non-negotiable, as even short-term exposure can be harmful. Seal food, medications, and personal items in airtight containers or remove them entirely. Use professional-grade equipment to monitor chemical levels, such as formaldehyde test kits, which can detect concentrations as low as 0.01 parts per million (ppm). Proper ventilation is also critical; open windows and use fans to disperse fumes after the process, but only once the fumigant has had time to work effectively, typically 8–12 hours depending on the product.
Protective gear is essential for anyone involved in the fumigation process. Workers should wear respirators with organic vapor cartridges, chemical-resistant gloves, goggles, and full-body suits. For DIY applications, N95 masks are insufficient; instead, opt for a respirator rated for the specific fumigant being used. Children, pregnant individuals, and those with pre-existing respiratory conditions, such as asthma, are particularly vulnerable and should avoid the area until it is fully ventilated and tested for chemical residues. Post-fumigation, hire a certified inspector to ensure chemical levels are safe, typically below 0.1 ppm for formaldehyde.
Comparing fumigation to alternative methods highlights its risks. Unlike HEPA vacuuming or physical removal, fumigation relies on toxic chemicals that linger if not properly managed. For example, ozone generators, sometimes used for mold remediation, produce a gas that can damage lung tissue at concentrations above 0.1 ppm. While effective, these methods require expertise and strict adherence to safety protocols. In contrast, physical removal, though labor-intensive, avoids chemical exposure altogether. Weighing these options underscores the importance of treating fumigation as a last resort and prioritizing safety at every step.
Long-term safety measures cannot be overlooked. After fumigation, monitor the treated area for mold recurrence, as spores can survive in hidden areas. Regularly inspect for moisture sources, such as leaks or condensation, which fuel mold growth. Use dehumidifiers to maintain indoor humidity below 50%, and ensure proper insulation to prevent condensation. Educate occupants on early signs of mold, such as musty odors or discolored walls, to address issues promptly. By combining immediate safety precautions with ongoing prevention, fumigation can be a safe and effective solution, but only when executed with meticulous care.
Do Chytrids Have Flagellated Spores? Unveiling Fungal Mysteries
You may want to see also

Alternatives to fumigation for mold removal
Fumigation, while effective against many pests, often falls short when it comes to mold spores due to their resilience and ability to remain dormant until conditions are favorable for growth. This limitation has spurred the development of alternative methods that target mold more directly and sustainably. Among these, physical removal and cleaning stand out as the most reliable approach. Mold thrives in damp, organic environments, so the first step is to identify and eliminate the moisture source. Once the area is dry, scrub affected surfaces with a mixture of detergent and water, followed by a thorough rinse. For porous materials like drywall or carpet, removal and replacement are often necessary, as spores can penetrate deeply and recur. This method is labor-intensive but ensures that both visible mold and its root causes are addressed.
For those seeking a chemical solution without the toxicity of fumigation, natural and commercial mold removers offer viable alternatives. Vinegar, a mild acid, can kill 82% of mold species and is safe for most surfaces. Apply undiluted white vinegar to the affected area, let it sit for an hour, then scrub and wipe dry. Hydrogen peroxide (3% concentration) is another effective option, particularly for bathroom mold, as it not only kills spores but also lightens stains. Commercial products like Concrobium Mold Control work by creating a barrier that prevents mold from returning, making them ideal for long-term prevention. Always test these solutions on a small area first to avoid surface damage.
HEPA filtration and dehumidification are preventive measures that complement active mold removal. Mold spores are microscopic and can spread through the air, so using a HEPA air purifier helps capture them before they settle and grow. Pair this with a dehumidifier to maintain indoor humidity below 50%, as mold requires moisture to thrive. For larger spaces or persistent issues, consider professional-grade equipment like desiccant dehumidifiers, which are more effective in colder temperatures than traditional refrigerant models. Regularly cleaning filters and drainage systems ensures these devices operate efficiently.
In cases of severe or recurring mold, professional remediation is often the most effective alternative to fumigation. Certified mold specialists use advanced techniques like dry ice blasting, which removes mold without damaging surfaces, or soda blasting, which uses sodium bicarbonate to clean and deodorize. These methods are particularly useful for historical buildings or sensitive materials. Professionals also conduct thorough inspections to identify hidden mold and provide tailored solutions, ensuring the problem is fully resolved. While costly, this approach saves time and prevents long-term health risks associated with improper removal.
Finally, preventive measures are the most cost-effective alternative to fumigation. Regularly inspect areas prone to moisture, such as basements, attics, and bathrooms, for early signs of mold. Improve ventilation by using exhaust fans or opening windows during humid activities like cooking or showering. Apply mold-resistant paints and sealants in high-risk areas, and promptly repair leaks in roofs, pipes, or walls. Educating household members on mold prevention, such as wiping down wet surfaces and avoiding carpet in damp areas, can significantly reduce the likelihood of mold recurrence. By addressing the root causes, these strategies eliminate the need for drastic measures like fumigation.
Are Spores Dead or Alive? Unraveling the Mystery of Their State
You may want to see also
Frequently asked questions
Yes, fumigation can effectively kill mold spores by using chemicals like chlorine dioxide or formaldehyde to penetrate surfaces and eliminate them.
No, the effectiveness depends on the fumigant used. Some chemicals, like chlorine dioxide, are more effective at killing mold spores than others.
Fumigation kills existing mold spores but does not prevent future growth. Addressing moisture sources and improving ventilation is essential to avoid recurrence.
Fumigation can be safe if conducted by professionals, but it requires occupants to vacate the premises temporarily due to the use of toxic chemicals. Proper ventilation is crucial afterward.

























